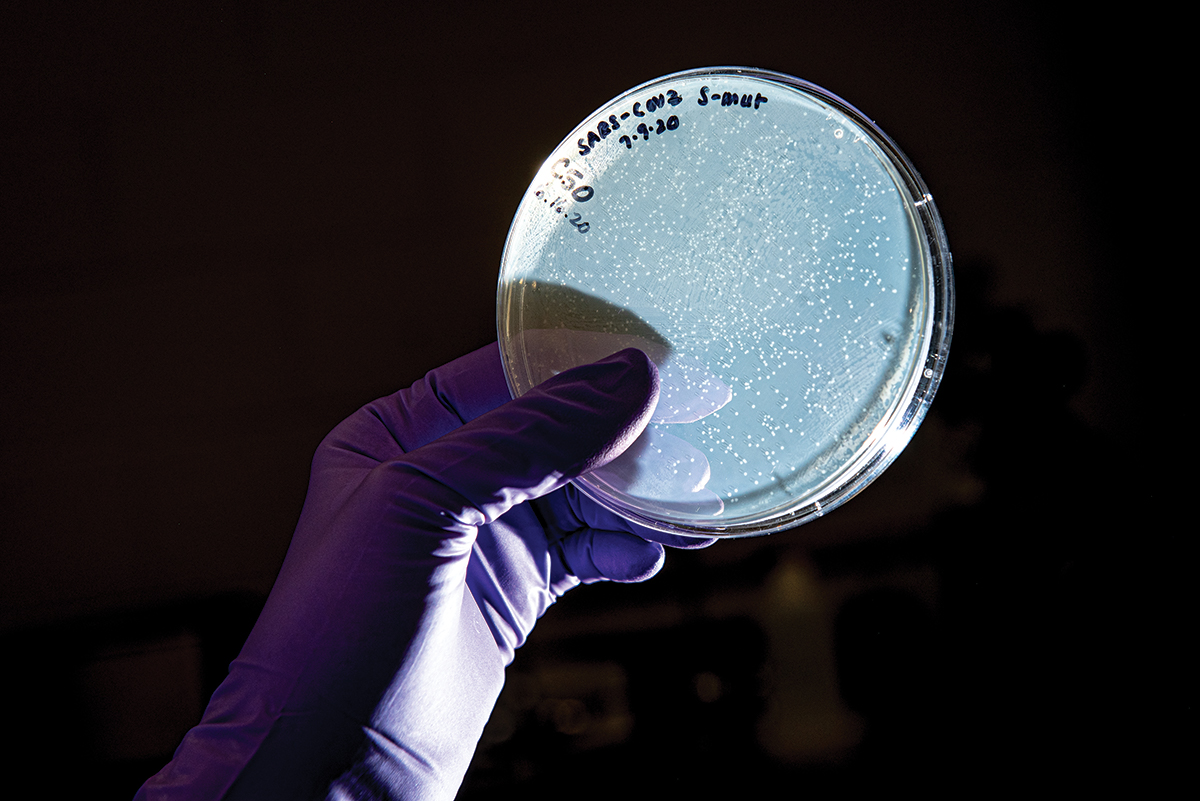
SARS-CoV-2 on a petri dish

A pandemic battle
By Erin Pennington and Jennifer Tidball
Additional stories
Read more stories about COVID-19 research at Kansas State University.
By now, we all know the key phrases that describe the COVID-19 pandemic. They are familiar snippets we have heard many times during this period of history. Loss of taste and smell. Cases spreading. Hundreds of thousands of deaths. Staying home. Record unemployment. Economic collapse. No treatment and no vaccine.
At the center of everything is a newly emerged coronavirus called SARS- CoV-2, which causes COVID-19. In its name, CO stands for corona, VI for virus, D for disease and 19 for the year 2019 when it emerged. This highly contagious and difficult-to-treat virus is covered in spikes — similar to the jewels on a crown, or corona — that attach to the cells in our bodies.
There is no denying that the pandemic has affected nearly every aspect of our daily lives. Things look different now. We wear face coverings. We stand 6 feet apart. We practice behaviors to mitigate the spread of the virus.
Kansas State University researchers are helping by battling the pandemic from multiple angles: understanding the virus, exploring vaccines and treatment options, improving COVID-19 tests, 3D-printing test materials and assisting communities.
The solutions during this COVID-19 pandemic come through a multifaceted approach led by the state’s land-grant university.
“As the country’s first operational land-grant university, K-State has always risen to the occasion to help our state and country through difficult times,” said Richard Myers, K-State president. “The current COVID-19 pandemic is no different and our researchers continue to lead the way through important work across disciplines. Together, we will battle this pandemic.”
Answering the call

While it has been a K-State research asset for more than 10 years, the Biosecurity Research Institute, or BRI, was created for historic moments like the current global pandemic. The BRI, in Pat Roberts Hall, is a biosafety level-3 facility where researchers can safely study infectious diseases that affect plant, animal and human health. Zoonotic viruses, which are viruses such as SARS-CoV-2 that spread between animals and humans, are one of the areas of focus at the BRI.
Since the beginning of the COVID-19 pandemic, scientists and staff at the BRI have ramped up research on SARS-CoV-2 in an “all hands on deck” approach to fighting a virus that affects us all. Under the leadership of Director Stephen Higgs, the BRI quickly began new research programs related to SARS-CoV-2 and built on existing infectious disease research and training programs.
“Time is of the essence when responding to a new biological threat,” Higgs said. “I am proud of the work we are doing at K-State to learn as much as we can about SARS-CoV-2 and other dangerous pathogens.
This work is possible because of the unique capabilities of the BRI and the dedicated BRI and institutional staff.”
The BRI provides the secure environment, training and infrastructure required for research on SARS-CoV-2. It is adjacent to the federal National Bio and Agro-Defense Facility, or NBAF, which is under construction and will be America’s foremost animal disease research facility. NBAF is a biosafety level-3 and biosafety level-4 laboratory that will replace the aging Plum Island Animal Disease Research Center in New York.
Research facilities such as the BRI have brought K-State and the state of Kansas into the national and international spotlight for important biosecurity work during the current pandemic.
State leaders recognize the importance of the BRI and the research conducted there. Kansas Gov. Laura Kelly toured the BRI in August to meet with researchers and learn more about their work fighting COVID-19 and other diseases that affect human, animal and plant health.
“The Kansas State University Biosecurity Research Institute has a long history of excellence and innovation researching disease spread like what we are currently facing with COVID-19,” Gov. Kelly said after the visit. “My conversations with BRI staff served as a reminder of how many of our best and brightest have answered the call to help end the pandemic.”
BRI researchers have answered the call and completed six projects related to COVID-19 since March, in addition to many ongoing coronavirus research projects.
A new zoonotic disease

Some of the BRI research focuses on the zoonotic potential of SARS-CoV-2 to pass between animals and humans.
Researcher Jürgen A. Richt has completed several coronavirus projects at the BRI. Richt is the Regents distinguished professor in the diagnostic medicine and pathobiology department and director of the Center on Emerging and Zoonotic Infectious Diseases, or CEZID, in the College of Veterinary Medicine.
His work focuses on five areas: animal susceptibility and transmission of SARS-CoV-2, virus stability on surfaces, therapeutic treatments, diagnostics and vaccines. Richt and his colleagues have found evidence that SARS-CoV-2 is more stable under spring and fall conditions than under summer conditions on various surfaces. The work was recently published in a non-peer-reviewed paper on bioRxiv.org.
He has found that pigs do not seem to be susceptible to coronavirus, but little is known if the virus affects cattle, sheep, chickens or wildlife. He is further researching if other livestock may be susceptible to coronavirus.
Domestic cats are susceptible to feline coronaviruses and Richt’s team is studying if domestic cats can carry and spread SARS-CoV-2. The team has found that cats are a potential host species for SAR-CoV-2, and even asymptomatic cats can transmit the virus to other cats. They have published the non-peer-reviewed study on bioRxiv.org.
“This study is critical in understanding the role of companion animals in the ecology of SARS-CoV-2,” Richt said. “We must continue to study SARS-CoV-2 to better understand potential virus reservoirs such as cats as well as its potential transmission to other animals and humans.”
The study is one of several COVID-19-related studies. Separate studies have been published on bioRxiv.org and have looked at the susceptibility of swine cells and domestic pig cells to the SARS-CoV-2 virus.
Richt also serves on an expert panel for the World Health Organization, which has tasked the group with developing COVID-19 preclinical models for the evaluation of vaccines and therapeutics.
One of Richt’s collaborative projects involves Sumit Chanda with the Sanford Burnham Prebys Medical Discovery Institute, Nevan Krogan with the University of California San Francisco and Adolfo García-Sastre with the Icahn School of Medicine at Mount Sinai. The project has involved repurposing existing drugs that have been in human clinical trials or approved by the Food and Drug Administration, or FDA, for treating diseases such as cancer, leprosy, Crohn’s disease and other illnesses.
The researchers used a National Institutes of Health library of 12,000 drugs and tested them for efficacy against COVID-19 in cell cultures to see if they inhibited SARS-CoV-2 replication. They have narrowed the list of drugs down to about two dozen potentially effective drugs. Richt is now testing these potential antiviral drugs in preclinical models.
“We are on the front end of studying whether these drugs, which look very promising in cell culture assays, can be used in COVID-19 patients,” Richt said. “We hope that the work we are doing presently will save lives.”
Richt’s research is supported in part by the National Bio and Agro-Defense Facility Transition Fund provided by the state of Kansas, the U.S. Department of Homeland Security and the National Institutes of Health.
Mosquitoes and the virus
Stephen Higgs led a collaborative study that is the first to confirm that SARS-CoV-2 cannot be transmitted to people by mosquitoes. The study, published in Nature Scientific Reports, found that the virus cannot replicate in three common mosquito species — Aedes aegypti, Aedes albopictus and Culex quinquefasciatus — and, therefore, cannot be transmitted to humans by mosquitoes.
“While the World Health Organization has definitively stated that mosquitoes cannot transmit the virus, our study is the first to provide conclusive data supporting the theory,” said Higgs, Peine professor of biosecurity and university distinguished professor of diagnostic medicine and pathobiology.
The study involved BRI and College of Veterinary Medicine collaborators in diagnostic medicine and pathobiology, including Yan-Jang Huang, research assistant professor; Dana Vanlandingham, professor; and Ashley Bilyeu, Susan Hettenbach and Haelea Sharp, all research assistants.
The research was in part supported by the National Bio and Agro-Defense Facility Transition Fund provided by the state of Kansas.
Blocking the spike
K-State has signed four COVID-19-related licensing agreements with companies for vaccine candidates and possible antiviral drugs. All the licensing agreements have been coordinated through K-State Innovation Partners.
In one research agreement with clinical-stage biopharmaceutical company Tonix Pharmaceuticals, scientist Waithaka Mwangi is studying a COVID-19 vaccine candidate at the BRI. The research is based on a new vaccine platform that his team developed for bovine parainfluenza 3 virus, known as BPI3V, which is closely related to human parainfluenza 3 virus.
Mwangi, professor of diagnostic medicine and pathobiology in the College of Veterinary Medicine, and his team have focused on the most critical protein of coronaviruses: the spike protein. When a person is exposed to the virus, this protein is involved in the infection of the host cell. The vaccine candidate developed at K-State has been engineered to display the spike protein in a manner that mimics the actual virus.
Instead of being injected, Mwangi’s vaccine candidate could be sprayed in the nose to trigger immune protection and block the virus’s spike protein from infecting the host cells. The vaccine also would induce T-cell responses capable of killing infected cells.
Antiviral drugs and treatment
One problem during the COVID-19 pandemic is that there are not yet any antiviral drugs for human coronaviruses.
Two virologists in the College of Veterinary Medicine, Yunjeong Kim and Kyeong-Ok “KC” Chang, are trying to solve this problem by discovering a treatment for COVID-19. They have signed two licensing agreements with Cocrystal Pharma Inc., which is a clinical-stage biotechnology company, and another licensing agreement with Anivive Lifesciences, which develops companion animal and human medicines.
“Vaccine developments and treatments are the biggest targets in COVID-19 research,” said Chang, professor of diagnostic medicine and pathobiology.
One of the licensing agreements grants Cocrystal the use of two series of protease inhibitors that Kim and Chang developed and patented.
“Protease inhibitors bind and block the function of the virus protease,” said Kim, associate professor of diagnostic medicine and pathobiology. “Those virus proteases are essential enzymes for virus replication, so if you bind and block them, then the virus cannot replicate anymore.”
Cocrystal is moving forward with the preclinical research on the patented compounds and will then complete additional steps, such as pharmacokinetics and eventually clinical trials. Kim said the ultimate goal is that one of the compounds will become a drug that can be licensed by the FDA as a possible treatment of the coronavirus infection that causes COVID-19.
Another licensing agreement with Cocrystal includes antiviral compounds with a focus on norovirus and Middle East respiratory syndrome, known as MERS. The company intends to pursue research and development of theses antiviral compounds, including preclinical and clinical development.
Kim and Chang also recently published a study about the licensed potential COVID-19 therapeutic treatment in the prestigious medical journal Science Translational Medicine.
Kim and Chang have spent years developing antiviral compounds to combat devastating viral animal and human diseases, from feline coronaviruses to human coronaviruses, noroviruses and rhinoviruses. They have received National Institutes of Health funding and collaborated with teams led by Bill Groutas at Wichita State University, Stanley Perlman at the University of Iowa and Scott Lovell at the University of Kansas.
“Drs. Chang and Kim have been working on antivirals and inhibitors for SARS and MERS at K-State for a number of years, so discoveries related to corona and noroviruses are really not surprising,” said Peter K. Dorhout, K-State vice president for research. “Some of the discoveries they’ve made about treating fatal feline coronavirus translate nicely into understanding the current SARS-CoV-2 virus, emphasizing the important, critical connection between basic virology research on animal and human diseases.”
Building better tests
Another issue throughout the pandemic has been testing, including shortages of testing supplies and challenges with testing results. Several K-State and community partnerships are helping on both fronts.
By partnering with the BRI, the Kansas State Veterinary Diagnostic Laboratory, or KSVDL, has performed thousands of COVID-19 tests since the pandemic began and has maintained a quick turnaround time. Researchers are performing overflow tests for the Kansas Department of Health and Environment, or KDHE, and they are processing student and employee tests from Lafene Health Center at K-State. The KSVDL also routinely provides COVID-19 testing for six community partners.
“Because of planning and preparation with the BRI over the last few years concerning foreign animal disease, as part of the National Animal Health Laboratory Network, KSVDL was able to respond quickly to the request to assist with human pandemic testing,” said Jamie Henningson, KSVDL director.
KSVDL researchers are developing better COVID-19 tests, too. The KSVDL Molecular Research and Development team has been working on a fast polymerase chain reaction, or PCR, test, which detects the presence of viral genetic material earlier to determine if a person has the virus. The PCR test is a widely used test, but the K-State test uses a single PCR reaction for each sample instead of the three PCR reactions that are normally needed.
“The multiplex assay has been validated with a number of positive and negative samples from human patients,” said Jianfa Bai, professor and section head of the Molecular Research and Development team. “An emergency use authorization application has been filed with the FDA for the assay, which will speed up the detection process three times that of the Centers for Disease Control and Prevention protocol.”
A state commendation

A K-State and community partnership has received recognition from the Kansas Department of Health and Environment, or KDHE, for collaborative efforts to make COVID-19 testing supplies available.
K-State has teamed up with Community HealthCare System and the Northeast Kansas Healthcare Coalition to successfully fill the supply chain gap of nasopharyngeal swabs for COVID-19 testing in the region. Researchers in the Carl R. Ice College of Engineering are 3D-printing testing swabs to use at clinics and hospitals in northeast Kansas, including Onaga, St. Marys, Seneca and Holton.
K-State administrators and faculty members involved include Beth Montelone, senior associate vice president for research; Jungkwun Kim, assistant professor and Michelle Munson-Serban Simu Keystone research scholar in the Mike Wiegers Department of Electrical and Computer Engineering; and Dong Lin, assistant professor of industrial and manufacturing systems engineering and Don and Linda Glaser Keystone research scholar.
Both Kim and Lin specialize in research related to 3D printing. Kim specializes in 3D microfabrication and Lin studies 3D printing and manufacturing composites. See page 12 for more about Lin’s research.
The group was recognized in a virtual ceremony of commendation with KDHE Secretary Lee Norman, M.D.
“On behalf of KDHE, I want to thank Dr. Montelone and Dr. Kim for their contributions in helping solve a problem that we had during this pandemic of COVID-19: a short supply of a particular item, the nasal swabs,” Norman said. “It really is very illustrative that something kind of minor can really stop the presses. The Northeast Kansas Healthcare Coalition, Community Healthcare System and K-State met this need in a very creative way, which provided these much-needed swabs — not just to KDHE, but to hospitals, clinics, etc.”
K-State has printed and donated more than 7,000 swabs and continues to print more.
“This is just something K-State has done throughout its history — we are the land-grant university for the state of Kansas and it’s in our mission to do research and extension for the greater good,” Montelone said.
From all angles
The battle against COVID-19 crosses disciplinary boundaries. Kansas State University researchers are tackling all dimensions of the pandemic.
Leading an open source
K-State is leading a new research consortium that uses artificial intelligence to find promising drugs for COVID-19 treatment.
Ho-Leung Ng, associate professor of biochemistry and molecular biophysics in the College of Arts and Sciences, is the founder of the Open Source COVID-19 research consortium that is using computational chemistry to speed up the process of finding COVID-19 drug treatments.
The consortium is making all findings from its researchers freely available to others worldwide. Along with K-State, main host universities include the Wistar Institute in Philadelphia and the University of Toronto in Canada. Intel is the research sponsor.
Protecting processing facilities
A K-State team is studying how to effectively control the spread of SARS-CoV-2, the virus that causes COVID-19, in meat and poultry processing facilities. The researchers are protecting plant workers and their surrounding communities by evaluating potential sources of exposure and identifying, developing and validating cleaning and disinfection strategies.
A $1 million grant from the U.S. Department of Agriculture is funding the project along with $330,000 from the State of Kansas National Bio and Agro-Defense Facility Transition Fund for research at the K-State Biosecurity Research Institute.
The project involves College of Veterinary Medicine, College of Agriculture and Food Science Institute researchers, including A. Sally Davis, assistant professor of experimental pathology and project director; Randy Phebus, co-project director and professor of animal sciences and industry; Jeanette Thurston, director of the Food Science Institute and co-investigator on the project; and many other collaborators.
Modeling the virus spread
Researchers in the Carl R. Ice College of Engineering have been modeling the spread of COVID-19 to create short-term forecasts and long-term mitigation strategies.
During the initial spread of the virus in China, Caterina Scoglio, the LeRoy and Aileen Paslay professor in the Mike Wiegers Department of Electrical and Computer Engineering, led a team that accurately predicted and modeled the daily cases reported in Wuhan City. Their simulation results have shown that without continued control measures, the epidemic in the province of Hubei would have become more persistent. They published the research in the journal Infectious Disease Modeling and also have received a National Science Foundation Rapid Response Research grant to continue modeling the spread of COVID-19.
Scoglio and her research team also have developed a computer simulation that revealed beef supply chain vulnerabilities that need safeguarding, which is a realistic concern during the COVID-19 pandemic.
Becoming a cyber land-grant university
As colleges and K-12 schools across the country incorporate remote and hybrid instruction models, several K-State teams are helping navigate the world of online learning.
A multidisciplinary team of researchers in the College of Education has identified the top needs and challenges of K-12 teachers during the COVID-19 pandemic through a study involving 800 teachers in rural, urban and suburban schools in Kansas.
In another project, Thomas Vontz, professor of curriculum and instruction, coordinated the Remote Learning P-12 community, which is a free digital resource for sharing innovative ideas and resources that support student success. The online forum is open to parents, teachers, principals, superintendents and school counselors in Kansas and around the nation and world.
In addition to Keep Teaching and Keep Learning websites available for K-State faculty, students and staff, the K-State Global Campus also has developed the Keep Teaching: Resources for Higher Ed online community. The online space includes faculty, library staff, information technology professionals and administrators who are from universities around the world and are sharing valuable information on teaching and learning remotely.
Helping the agricultural industry
The COVID-19 pandemic has affected nearly all aspects of the agricultural industry, from health and safety in meat processing facilities to food security and economic resources. College of Agriculture researchers have been helping since the beginning of the pandemic.
When flour shortages occurred in the early months of the pandemic, the grain science and industry department and the Hal Ross Flour Mill manufactured flour to provide basic food supplies for local people in need. The group handed out 15,000 pounds of flour in 10-pound bags in a single day to local residents.
The Kansas economy is directly and substantially affected by anything that alters agriculture in the state. Glynn Tonsor, professor of agricultural economics, has been studying livestock prices during the pandemic and providing information and guidance to help the livestock Sector.
K-State Research and Extension, or KSRE, also has been helping Kansans across the state with research-based information and programs. The agricultural economics department, in partnership with KSRE, has been maintaining and updating the AgManager website, which includes valuable resources for livestock and agricultural communities. The College of Agriculture and KSRE also produce radio programs and webinars focused on relevant COVID-19 topics.
Monitoring mental health
The K-State Family Center, a therapy training and service center in the College of Health and Human Sciences, has continued offering teletherapy and helping people cope with COVID-19-related mental health concerns, including financial stress, child care and school issues, concerns about health, grief over canceled events and activities, and increased social isolation.
Megan McCoy, professor of practice in personal financial planning, also has been helping couples cope with financial stress and anxiety during the pandemic. She consulted with Morningstar to aid in the development of a new financial therapy digital tool called MoneyTalk.
K-State Research and Extension specialists Bradford Wiles, associate professor of applied human sciences, and Elizabeth Kiss, associate professor of personal financial planning, have published information for parents and communities to help children cope during hard times.